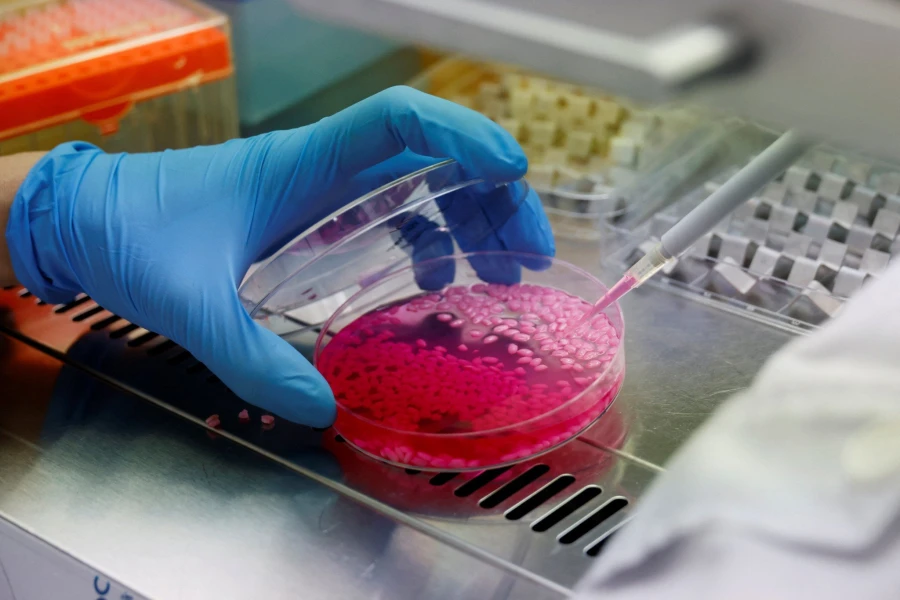
Reuters

Βοδινό ρύζι πλούσιο σε πρωτεΐνη.... σύντομα στα πιάτα σας!
Διασταύρωση κρέατος και ρυζιού κατασκεύασαν επιστήμονες στη Νότια Κορέα, υποστηρίζοντας πως πρόκειται για μια προσιτή και ταυτόχρονα φιλική προς το περιβάλλον πηγή πρωτεΐνης.
Νοτιοκορεάτες ερευνητές κατάφεραν να καλλιεργήσουν κύτταρα βοείου κρέατος σε κόκκους ρυζιού, τα οποία, όπως λένε, θα μπορούσαν να γίνουν μια βιώσιμη εναλλακτική πηγή πρωτεΐνης που μπορεί να αντικαταστήσει τα εκτρεφόμενα βοοειδή για το κρέας.
Ο καθηγητής Τζίνκι Χονγκ του Πανεπιστημίου Yonsei στη Σεούλ, ο οποίος ηγήθηκε της έρευνας, είπε λέει ότι το «βόειο ρύζι» είναι το πρώτο στο είδους του που χρησιμοποιεί σωματίδια κόκκων ως βάση για την καλλιέργεια ζωικών μυών και λιπωδών κυττάρων.

«Οι κόκκοι ρυζιού που βλέπετε τώρα έχουν μια ομοιόμορφη κατανομή τόσο των μυϊκών όσο και των λιπωδών κυττάρων σε όλη την επιφάνεια και το εσωτερικό τους, ανοίγοντας το δρόμο για την ανάπτυξη μελλοντικών πηγών τροφίμων».
Στην έρευνα οι κόκκοι ρυζιού υποβλήθηκαν σε επεξεργασία με ένζυμα για τη δημιουργία ενός βέλτιστου περιβάλλοντος για την ανάπτυξη των κυττάρων και στη συνέχεια εγχύθηκαν με κύτταρα βοοειδών που καλλιεργήθηκαν εργαστηριακά για να επιτευχθεί το τελικό υβριδικό προϊόν που μοιάζει με ροζ κόκκο ρυζιού. Το αποτέλεσμα περίπου 8% περισσότερη πρωτεΐνη και 7% περισσότερα λιπαρά από το συμβατικό ρύζι. Και η γεύση είναι επίσης διαφορετική.
«Εκτός από μια ελαφριά μοσχαρίσια γεύση που ακολουθείται από μια γεύση πρωτεΐνης φυτικής προέλευσης, υπάρχει επίσης μια λεπτή βουτυρώδης κρεμώδης γεύση, και επιπλέον, υπάρχει μια ελαφριά ξηρότητα. Από την προσωπική μου εμπειρία, έχει το χαρακτηριστικό μια παρατεταμένης επίγευσης».
Η ομάδα του Yonsei δεν είναι η πρώτη που προσπαθεί να φέρει στο τραπέζι προϊόντα κρέατος που καλλιεργούνται στο εργαστήριο. Εταιρείες σε όλο τον κόσμο έχουν λανσάρει καλλιεργημένο κρέας. Ένα από τα τελευταία περιλαμβάνει κοτόπουλο και χέλι φυτικής προέλευσης που καλλιεργούνται από βάση σόγιας διατίθενται στο εμπόριο στη Σιγκαπούρη.
Ωστόσο, από την πλευρά της η ομάδα του Hong λέει ότι το ρύζι έχει ένα πλεονέκτημα όσον αφορά την ασφάλεια σε σχέση με τη σόγια ή τους ξηρούς καρπούς, επειδή λιγότεροι άνθρωποι είναι αλλεργικοί σε αυτό.
Με τιμή περίπου 2 δολάρια ανά κιλό και με πολύ μικρότερο αποτύπωμα άνθρακα, η ομάδα υποστηρίζει ότι το καλλιεργημένο βοδινό ρύζι μπορεί να ανταγωνιστεί επάξια τα παραδοσιακά προϊόντα βοείου κρέατος.

Ωστόσο ξεκαθάρισαν ότι η πρόκληση ενός τέτοιου εγχειρήματος δεν έγκειται μόνο στο τεχνικό κομμάτι, όσο στο να κερδίσεις πελάτες με τη σωστή γεύση και υφή.
Εθελοντές που δοκίμασαν το βοδινό ρύζι λένε ότι είναι μια καινοτόμος ιδέα αλλά δεν μπορεί σε καμία περίπτωση να αντικαταστήσει σε μόνιμη βάση το φυσικό κρέας.







